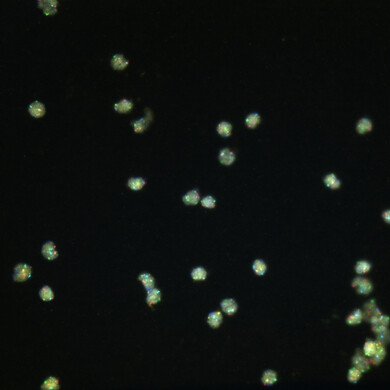
Logo e identità visiva di Ikonisys, azienda specializzata in diagnostica cellulare.

Azioni Small & Mid Cap
Notizie
Tmp Group - Verso un nuovo Cda dopo le dimissioni di un consigliere
Per effetto di una specifica previsione statutaria, volta a garantire stabilità, il venir meno della…
Notizie
Cy4Gate - Antifrode, siglato un contratto da 5,6 milioni di euro
La società registra un forte interesse per tecnologie a supporto dei processi di prevenzione e prote…
Notizie
GPI - Nuovo patto parasociale tra FM e CDP Equity
Il patto ha durata triennale, con espressa esclusione del rinnovo tacito, ed è finalizzato a discipl…
Notizie
SG Company - Geotag acquisisce Waymedia per rafforzarsi nel Lazio
Il prezzo è stato concordato in 750mila euro, da corrispondersi il 5 tranche semestrali, importo che…
Notizie
Cube Labs - Scienze della Vita, rinnovato l'accordo con l'INBB
Si tratta del principale consorzio interuniversitario di ricerca italiano del settore, a cui aderisc…
Notizie
Somec - Navi da crociera, nuove commesse da oltre 21 milioni di euro
La consegna delle navi è prevista tra il 2028 e il 2032, mentre la ricaduta economica delle commesse…
Notizie
GPI - Cerved conferma il rating di credito
L'azienda possiede "fondamentali solidi e una buona capacità di far fronte agli impegni finanziari. …
Azioni Small & Mid Cap
FNM - Concessioni autostradali, aggiornato il sistema tariffario
La conclusione del procedimento contribuisce a una maggiore stabilità del contesto regolatorio e con…
Notizie
Aliko Scientific - Aumento di capitale da 2,7 milioni di euro
Per gli analisti, l'operazione "rappresenta un chiaro segnale di validazione del piano industriale e…
Notizie
Helyx Industries - Annuncia la variazione del capitale sociale
A valle dell’operazione, il capitale sociale risulta pari a 260.498,87 euro, suddiviso in 26.049.587…
Notizie
Mare Group - Cede il ramo bandi a TradeLab e acquisisce Workgroup
L'azienda ha inoltre comunicato un significativo incremento della propria partecipazione in Eles, av…
Notizie
Banca Ifis - La due diligence chiesta da BCE rivela altre svalutazioni
L’impatto sarà incluso nei risultati preliminari al 31 dicembre 2025
Advertisement

Scopri di più su Advertisement